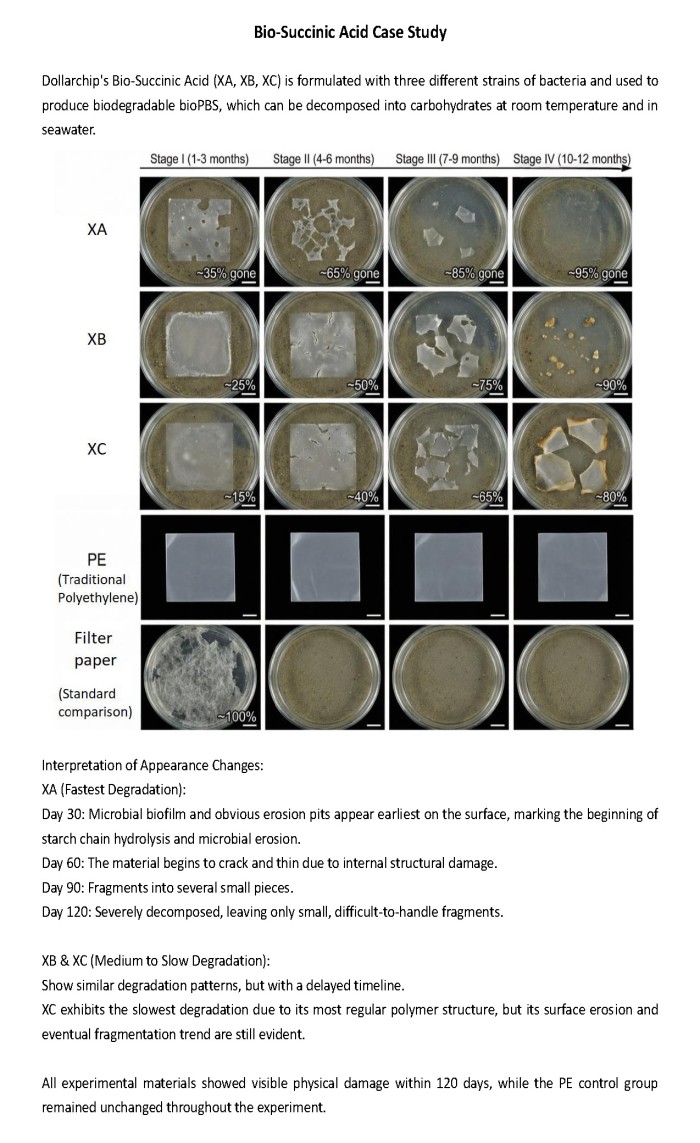

Home
List your patent
My account
Help
Support us
Bio-succinic acid
[Category : - Organic Chemistry]
[Viewed 31 times]
The invention relates to a sustainable bio-based production approach for biodegradable materials derived from agricultural starch resources. It integrates microbial fermentation and polymer design to convert low-cost renewable feedstocks, such as cassava or corn starch, into a new class of bio-based succinic-acid-derived materials.
The invention addresses key limitations of existing bio-plastics and petrochemical plastics, which often rely on expensive refined sugars, energy-intensive processes, or result in materials that degrade slowly or incompletely in marine environments. Conventional biodegradable plastics may fragment but persist as residues, creating environmental risks.
Compared with existing technologies, this invention offers economic and environmental advantages by simplifying upstream processing, improving carbon conversion efficiency, and enabling large-scale production using established fermentation infrastructure. The resulting materials are designed to degrade more effectively under natural conditions, reducing long-term environmental accumulation. Overall, the invention supports lower production costs, improved sustainability, and enhanced end-of-life performance relative to current bio-based and fossil-based alternatives.
Financial informationThe invention enables a cost-effective bio-based production route using widely available agricultural starch as raw material, reducing dependence on refined sugars and petrochemical inputs. The process integrates fermentation and material design to improve resource efficiency and product value. Compared with existing technologies, it lowers raw-material and processing costs while delivering materials with improved biodegradability, particularly in marine environments. This approach supports scalable manufacturing, reduces environmental remediation costs, and enhances market competitiveness for sustainable materials in packaging and industrial applications.
Patent publications:No publication
Asking price:
Make an offer

[ Home
| List a patent
| Manage your account
| F.A.Q.|Terms of use
| Contact us]
Copyright PatentAuction.com 2004-2017
Page created at 2026-01-05 16:58:04, Patent Auction Time.